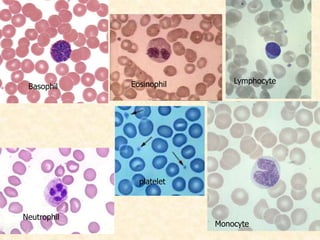
Basophil Eosinophil
Neutrophil
Lymphocyte
Monocyte
platelet

The document provides an extensive overview of blood's composition, functions, and physiological properties, highlighting its role as a liquid connective tissue that facilitates communication, transportation, regulation, and protection throughout the body. It details the components of blood including its cellular elements (red blood cells, white blood cells, and platelets) and plasma, as well as various blood properties such as pH, temperature, viscosity, and color, emphasizing their significance in maintaining homeostasis. Additionally, the document outlines the process of hematopoiesis and the developmental stages of blood cell formation in both fetal and postnatal life.